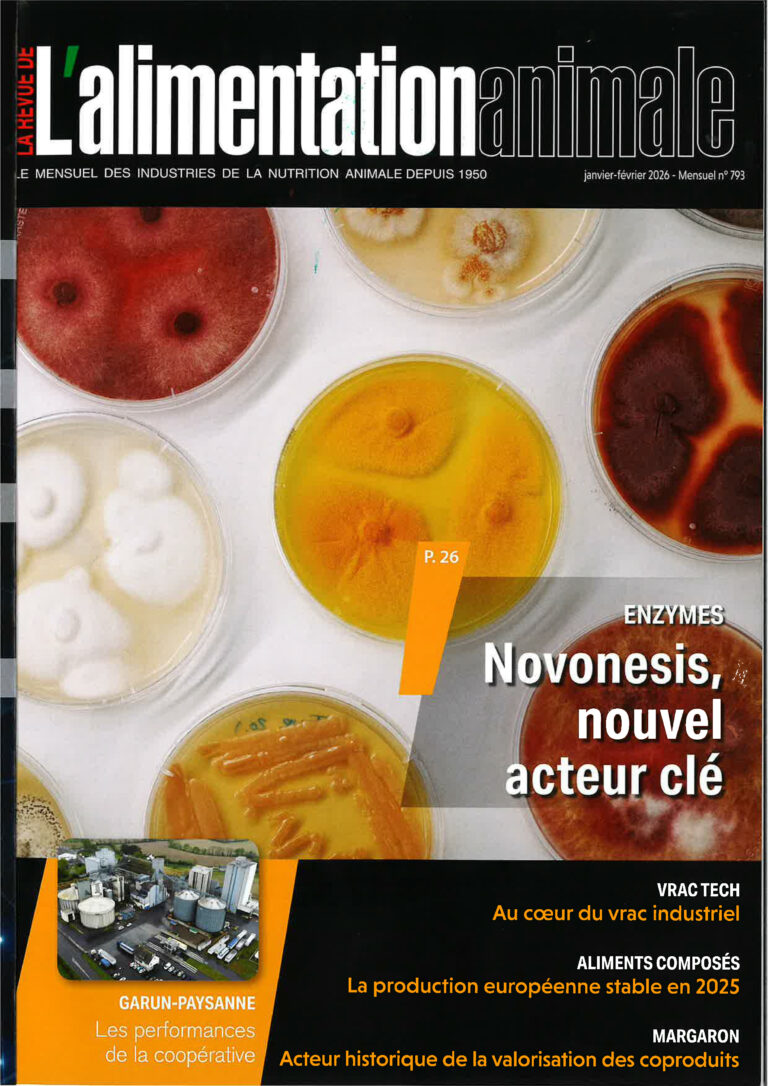

Presse
Réduire la taille des sacs – L’alimentation animale n°793 – Janvier et février 2026
15 janvier 2026
INFOVRAC – JUILLET 2025 – L’ensachage automatique sous vide ou atmosphère modifié : une solution à prendre en compte
30 juillet 2025
BIOENERGIE ETE 2025 – CETEC PLUS DE 50 ANS D’INNOVATIONS MADE IN FRANCE DEDIEES A L’ENSACHAGE
30 juillet 2025
INFOVRAC MAI 2025 – Le temps d’arrêt de la ligne : un facteur clé chez Borie
29 mai 2025
REVUE DE L’ALIMENTATION ANIMALE MAI 2025 – Réduire la taille des emballages avec le SLIMBAGGER
25 mai 2025